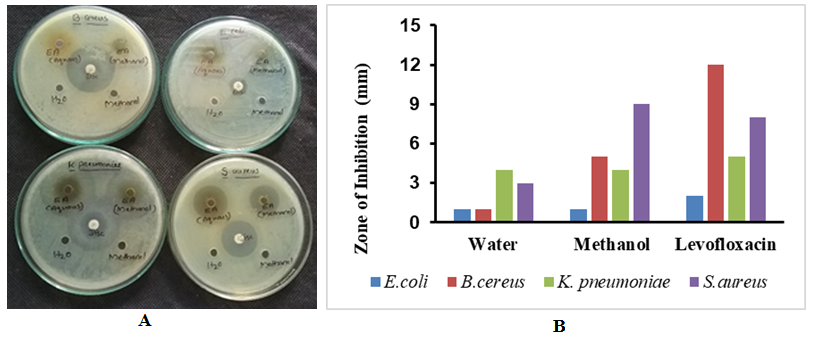

Int J Curr Pharm Res, Vol 15, Issue 1, 22-29Original Article
EVALUATION OF ANTIOXIDANT, ANTIMICROBIAL, ANTICANCER, AND WOUND HEALING PROPERTIES OF LEAF EXTRACTS OF ACANTHUS ILICIFOLIUS L.
SHAMEELA KHADEEJA A.*, JESTEENA JOHNEY, R. RAGUNATHAN
Department of Biotechnology, Centre for Bioscience and Nanoscience Research, Eachanari, Coimbatore, Tamilnadu 641021
*Email: shameelakhadeeja@gmail.com
Received: 15 Oct 2022, Revised and Accepted: 22 Dec 2022
ABSTRACT
Objective: To investigate the in vitro antioxidant, antimicrobial, anticancer, and wound healing properties of leaf extracts of Acanthus ilicifolius.
Methods: Acanthus ilicifolius leaves were dried and extracts were prepared using different solvents using cold extraction method. The preliminary phytochemical analysis and quantitative methods were carried out using standard procedures. In vitro antioxidant activity was evaluated using DPPH assay. Disc diffusion method was employed to determine the antimicrobial activities of the extracts. The methanolic extract was subjected to FTIR and GC-MS analysis for characterization of phytochemicals. This extract was further subjected to HPLC analysis for characterization and quantification. The antiproliferative effects of methanolic extract was determined using MTT assay and wound healing properties were determined using Cell migration assay.
Results: The highest levels of phenol and flavonoids were detected in aqueous extracts, followed by chloroform. Methanolic extract showed the highest antioxidant activity as well as significant antibacterial activity against Klebsiella pneumoniae and Staphylococcus aureus. Squalene, a metabolite with known pharmaceutical applications, was identified in GC-MS, which was further confirmed and quantified using HPLC analysis. The methanolic extract showed cytotoxic activity against the cervical cancer cell line and showed a significant beneficial effect on wound healing in the L929 cell line.
Conclusion: The results obtained in this study revealed that the leaf extracts of Acanthus ilicifolius possess potent antioxidant, antimicrobial, cytotoxic and wound-healing properties. These activities are due to bioactive components present in the extracts whose identification could lead to the development of new therapeutic agents.
Keywords: Acanthus ilicifolius, Phytochemical analysis, Mangroves, Anticancer activity, Antioxidant activity
© 2023 The Authors. Published by Innovare Academic Sciences Pvt Ltd. This is an open access article under the CC BY license (https://creativecommons.org/licenses/by/4.0/)
DOI: https://dx.doi.org/10.22159/ijcpr.2023v15i1.2066 Journal homepage: https://innovareacademics.in/journals/index.php/ijcpr
INTRODUCTION
Plant-derived secondary metabolites are compounds not required for the survival of the plant but do play a critical role in many processes. Based on their chemical structure, they are classified into phenolics, alkaloids, saponins, lipids, carbohydrates, terpenes, etc. These compounds have been determined to possess antimicrobial, antidiabetic, anticancer activity, antimalarial, and neuroprotective activity [1]. The presence of these biologically active compounds makes plant-derived metabolites an ideal source for the discovery of new drugs.
Mangroves, the flora found in the tropical and subtropical tidal regions are a good source of secondary metabolites with many rare compounds identified from them [2]. Due to the presence of these compounds having biological activity, they have been extensively used in traditional medicine [3]. Acanthus ilicifolius, widely found in tropical Asia and Africa [4], is used to treat diseases ranging from snake bites to skin diseases [5]. Phytochemicals derived from the plant have demonstrated significant pharmacological activities like antioxidant, anticarcinogenic, anti-osteoporotic, and hepatoprotective. Alcoholic extract of A. ilicifolius showed anticancer activity against L-929 lung fibroblast cell line as well as anti-tumorigenic activity against chemically-induced skin papilloma in mice [6].
Squalene, a linear tripeptide, is found abundantly in amaranth, olive, grape seed and soybean oil [7]. It finds pharmaceutical application in topical creams due to its high antioxidant, moisturizing and antimicrobial activity. Further, it is also known to have antineoplastic and cardioprotective activity [7]. Squalene isolated from Rhizophora mucronata showed antiproliferative activity against the gastric adenocarcinoma cell line [8].
In this present study, we performed a phytochemical analysis of the leaf extracts of Acanthus ilicifolius. Antioxidant and antibacterial activity of various extracts were conducted to determine their pharmacological value. UV-Visible spectrum, GC-MS analysis was performed to identify the multiple metabolites present in the extract. Squalene, a linear tripeptide, was detected in Acanthus ilicifolius extract. The leaf extract showed anticancer activity against the HeLa cell line and wound healing activity in the L929 cell line.
MATERIALS AND METHODS
Collection and Identification of leaf material
Fresh leaves of Acanthus ilicifolius L. were collected from the Mangalavanam Wird Sanctuary, Cochin, Kerala. The plant materials were identified from Tropical Botanical Garden and Research Institute (JNTBGRI), Kerala, India. The herbarium of Acanthus ilicifolius bearing collection number (Collection No. 95972) was deposited at the same Institute. The identity of the specimen was found to be correct as per the International Code of Nomenclature for algae, fungi, and plants (ICN).
Preparation of leaf extracts
The Fresh and healthy leaves were collected and washed thoroughly with running tap water to remove debris. The leaves were further dried in shades and then pulverised into a fine powder using a household blender and stored in an airtight container for further use. The powdered leaves were soaked (15g/100 ml) in different solvents of increasing polarity (petroleum ether, chloroform, ethanol, methanol, and water) overnight in a rotary shaker [9]. The extract obtained was stored in a refrigerator at 4 ℃ until further use. All the chemicals used in this preparation were procured from Hi-media, Sigma, and Spectrum (AR, LR).
Preliminary phytochemical analysis
Qualitative analysis
Qualitative phytochemical analysis was carried out according to the methods described earlier [9]. The results were observed based on the precipitate formation or colour change after addition of specific reagents.
Quantitative analysis
Total phenol
Each 0.5 ml extracts were mixed with 2.5 ml Folin-Ciocalteu reagent and 2 ml of 7.5% (w/v) Sodium carbonate. The mixtures were shaken and allowed to react for 30 min in the dark for 1 hour. Absorbance was measured at 765 nm, and Gallic acid was used as the standard. The total phenol content was determined as Gallic acid equivalents (GAE) in μg/g dry weight (DW) of the sample [9].
Total flavonoid
Total flavonoids were determined by the Aluminium chloride method [9]. An aliquot (1 ml) of extract was added to 0.3 ml of 5% (w/v) NaNO2 and incubated for 5 min. 0.3 ml AlCl3 (10% w/v) and 2 ml of 1N NaOH was added, and the total volume was made up to 5 ml with distilled water, and incubated for 10 min at ambient temperature. The absorbance was measured at 510 nm by using a UV-visible spectrophotometer. Three replicates were made for each test sample. The total flavonoid contents were expressed as Quercetin equivalence (QE) in mg/g.
In vitro free radical scavenging activity
Antioxidant potential was determined using DPPH [10]. To each extract, 1 ml of freshly prepared DPPH (200μM dissolved in ethanol) was added and vortexed thoroughly. Then the solution was incubated for 30 minin the dark. The absorbance of stable DPPH was recorded at 517 nm using UV visible spectrometer Shimadzu, UV-1800. Ascorbic acid was used as a standard. Percentage of inhibition was calculated using the formula.
% Inhibition = [1-(ABSSAMPLE/ABSCONTROL)] × 100.
Determination of antimicrobial activity
Clinical isolates of Escherichia coli (KY787193), Bacillus cereus (MT131177), Klebsiella pneumoniae (OL601967) and Staphylococcus aureus (MT126466) were procured from Centre for Bioscience and Nanoscience Research, Coimbatore, Tamil Nadu. Bacterial cultures were swab inoculated on the Mueller Hinton agar plates. Well diffusion method was employed to determine the antimicrobial activities of the extracts, the agar plates were incubated at 37 °C for 24 h [11] and the zones of inhibition were measured in millimeters. Commercial antibacterial disc Levofloxacin (5 µg) was used as positive controls; water and methanol were used as negative controls.
Fourier transform infrared spectroscopy (FT-IR) spectrum analysis
Based on the preliminary phytochemical screening, the methanolic extract of Acanthus ilicifolius was subjected for FTIR analysis. FT-IR spectra were recorded using Shimadzu FT-IR Spectrometer 8000 series in the region 4000–400 cm–1 by employing the standard KBr pellet technique. The extract was mixed with KBr salt, using a mortar and pestle, and compressed into a thin pellet.
GC-MS analysis
The analysis was performed using a GC-MS system (Agilent Technologies, USA) equipped with an HP-5 MS capillary column (30 m × 0.25 mm, 0.25 mm, Agilent Technologies USA). The injection volume of each sample was 1 µl. Helium (99.999%) was used as the carrier gas at a flow-rate of 1 ml/min. The temperature of the injection port was 250 ℃, and the column temperature program was as follows: 50 ℃ for 2 min, followed by an increase to 180 ℃ at a rate of 5 C/min, an increase to 270 ℃ at a rate of 20 ℃/min, and maintenance at 270 ℃ for 5 min. The MS conditions included an EI ion source temperature of 230 ℃, ionization energy of 70 eV, and a mass scan range of 40–500 amu.
Extracts preparation for HPLC characterization
For HPLC characterization and quantification, 1 mg of the sample was accurately weighed and dissolved in 1 ml of mobile phase/methanol. Mobile phase consisted of solvent A: Acetonitrile, solvent B: Acetone (in a ratio of 60:40). 1 mg of the standard (Squalene) was accurately weighed and dissolved in 1 ml of mobile phase/methanol and different concentrations of the standard were prepared by serial dilution. After filtration via PTFE filter, the sample and standard were put into HPLC vials. The analysis was carried out with Agilent 1260 series HPLC system (Agilent Technologies, USA) comprising a quaternary pump (Agilent Technologies 1260), a vacuum degasser, a variable wavelength detector set to 280 nm and a 20 µl sample injector. Flow rate is 1.0 ml/min. The separation was performed on the Zorbax Eclipse plus C18 column. Column specification is 3.5 µm, 100 mm × 4.6 mm, Agilent. The injection volume is set to 10 µl. The column thermostat was maintained at 30±1 °C.
Identification was through spiking with a squalene standard solution and spectral data of chromatographic peaks. Compounds were identified by comparing their retention times and UV spectra of the sample with those of the standard, while quantification was done by determining the percentage of peak area using the following one-point calibration formula.

Where Cx = Sample concentration, As = Standard peak area, Ax = Sample peak area, and Cs = Standard concentration.
Cell culture
HeLa (Human cervical adenocarcinoma cell line) and L929 (Mouse fibrosarcoma cell line) were purchased from National Centre for Cell Science, Pune, and have been maintained further in the Centre for Bioscience and Nanoscience Research laboratory Eachanari, Coimbatore, Tamil Nadu, India. The cell lines were subcultured in DMEM medium with the addition of sodium carbonate, glucose, and 10% FBS (Fetal Bovine Serum) and incubated at 37 °C, a humidity of 70-80% for 24-72 h. After incubation, the growth of the cell line was confirmed by viewing it under an inverted microscope and used for further study.
MTT assay
Cytotoxicity of the leaf extract was estimated using an MTT assay. Briefly, HeLa cells were seeded in 96-well plates and allowed to adhere for 24 h at 37 °C in 5% CO2 and 70-80% humidity. The cells were then subjected to DMSO (control), Doxorubicin (12.5µg) (positive control), and different concentrations of the drug and incubated for another 24 h. Following incubation, the cells were washed with DMSO and trypsin and then 20 µl of MTT dye was added to each well, the plates were mixed and incubated for another 24 h at 37 °C in a CO2 incubator. The reaction mixture was then carefully taken out and formazan crystals were solubilized by adding 100 µl of DMSO to each well and mixed thoroughly. After 24 h the absorbance of the purple colour was read at 570 nm using a 96 well plate ELISA reader (Robonik, India) after taking the reading, the percentage (%) of cell viability was calculated by given the formula.
% cell viability= [Mean abs of treated cells/Mean abs of Untreated cells] x 100
Wound healing assay
L929 cells (2.5x107 cells) were seeded into 12 well plates and incubated for 24 h to form a monolayer. Using a 200ul tip, held perpendicular to the bottom of the well, a vertical scratch was made. Detached cells following scratch preparation were removed by washing twice with the medium. Fresh medium without FBS along with control drug (conc), extract (conc) was added to the cells and grown for up to 48 h. Cell images were taken at different time intervals (0,12,24,48 h). Using Image J software, gap distances were quantitatively evaluated and the percentage of wound healing was scored.
% of Wound healing scored = (Initial area-Final area)/Initial area*100
RESULTS
Phytochemical analysis
The preliminary phytochemical analysis of Acanthus ilicifolius revealed the presence of important phytochemical compounds (table 1). The compounds, namely alkaloids, terpenoids and flavonoids, were present in both the aqueous and chloroform extracts. Phenol and flavonoid were present in all the extracts except petroleum ether. However, only aqueous extract showed the presence of quinines. However, there is no presence of saponins in any of the extracts tested. This is in agreement with the previous studies of Acanthus ilicifolius [12].
Table 1: Phytochemical constituents of Acanthus ilicifolius in different extracts
| S. No. | Phytochemical constituents | Acanthus ilicifolius | ||||
| W | M | E | C | P | ||
| 1 | Alkaloids | + | + | + | + | + |
| 2 | Terpenoids | + | + | + | + | + |
| 3 | Phenol | + | + | + | + | - |
| 4 | Sugar | + | - | - | + | - |
| 5 | Saponins | - | - | - | - | - |
| 6 | Flavinoids | + | + | + | + | - |
| 7 | Quinines | + | - | - | - | - |
| 8 | Proteins | + | - | - | - | - |
| 9 | Steroids | - | - | - | + | - |
W: Water, M: Methanol,E: Ethanol, C: Chloroform, P: Petroleum Ether,+: Present,-: Absent
Total phenol and flavonoids
The highest percentage yield of Phenol was obtained in both aqueous (86µg/g GAE) and chloroform (80µg/g GAE) extracts of Acanthus ilicifolius. Similarly higher yield of flavonoid content was obtained in aqueous (0.65 mg/g QE) extract followed by chloroform (0.283 QE) extracts of Acanthus ilicifolius (fig. 1).
Antioxidant activity
The antioxidant activity of Acanthus ilicifolius was determined for all the extracts. The result of the DPPH scavenging assay is shown in fig. 2. It is found that antioxidant compounds in all the extracts of Acanthus ilicifolius have exhibited free radical scavenging activity. The highest antioxidant potential was observed in methanol extract with 43.2% inhibition, followed by aqueous extract with 37.5%. However, the ethanol and chloroform extracts showed a low percentage of inhibition. The free radical scavenging activity may be due to alkaloids, terpenoids, and other flavonoids that act as primary antioxidants or free radical scavengers [13].
Antimicrobial activity of the plant extracts
Aqueous and methanolic extracts of Acanthus ilicifolius were screened for their antibacterial activity against Escherichia coli, Bacillus cereus, Klebsiella pneumoniae and Staphylococcus aureus by well diffusion method. Plant extracts with a final concentration of 50 mg/ml were used, while Levofloxacin disc (5 μg), a broad-spectrum antibiotic, was used as the positive control. Methanol extract of Acanthus ilicifolius showed maximum activity against Klebsiella pneumonia and Staphylococcus aureus, which was comparable to the activity shown by the antibiotic Levofloxacin (fig. 3).

A

B
Fig. 1: Graph showing A) total phenol content, B) Flavonoid content of different extracts of Acanthus ilicifolius

Fig. 2: Graph showing percentage inhibition of DPPH of different extracts of Acanthus ilicifolius
Fig. 3: Antibacterial activity of A) Acanthus ilicifolius. B) Graph depicting zone of inhibition for Acanthus ilicifolius on E coli, B Cereus, K pneumonia and S aureus
Fourier transform infrared spectroscopy (FT-IR) spectrum analysis
The FTIR spectrum of the methanolic extract of A. ilicifolius provides a lot of structural information on the major phytochemical constituents through peaks of various functional groups (fig. 4). The peaks at 2978.09, 2908.65 and 2831.50 cm-1 correspond to the C-H stretching bands; the peak at 1658.78 shows C=C. A broader peak observed at 3302.13 cm-1 corresponds to the-OH hydrogen bonding. Presence of the CH3 group is indicated by the characteristic peak at 1450.47 cm-1. 1018 cm-1 indicated the stretching vibration of the C-O-C group.

Fig. 4: FT-IR spectrum of methanolic extract of Acanthus ilicifolius
GC-MS analysis
The GC-MS profile of the methanolic extract of Acanthus ilicifolius identified several major phytochemical compounds (fig. 5). Few medicinally important phytoconstituents present in the extracts are Germacrene, Propanoic acid, alpha-Muurolene, Caryophyllene, 1-Hexadecanol, Octadecatrienoic acid, n-Hexadecanoic acid, Phytol, Oleic acid, Miltefosine, Vitamin E and Squalene (table 4). This wide variety of biologically active compounds indicates that these extracts may have potent therapeutic applications. However, further research is required to identify and purify the active compounds responsible for the therapeutic activity. Squalene has been identified as a major constituent in olive oil using GC-MS studies [14].

Fig. 5: GC-MS spectrum of methanolic extract of Acanthus ilicifolius
Table 4: List of few important phytochemicals present in GC-MS profile of methanol extract of Acanthus ilicifolius
| Retention time | Name of compound | Mol formula | Component area |
| 5.84 | 1-Dodecanol | C12H26O | 0.359 |
| 8.571 | Cyclohexane | C6H12 | 1.69 |
| 8.976 | Caryophyllene | C15H24 | 3.199 |
| 9.431 | Humulene | C15H24 | 0.406 |
| 9.751 | Germacrene D | C15H24 | 0.531 |
| 10.081 | 2,4-Di-tert-butylphenol | C14H22O | 0.3 |
| 10.131 | 1,5-Cyclodecadiene | C10H16 | 1.192 |
| 10.271 | Naphthalene | C10H8 | 1.838 |
| 11.412 | Caryophyllene oxide | C15H24O | 0.318 |
| 11.617 | 1-Hexadecanol | C16H34O | 0.806 |
| 16.704 | 2-Pentadecanone | C15H30O | 0.667 |
| 19.11 | n-Hexadecanoic acid | C16H32O2 | 8.692 |
| 21.781 | Phytol | C20H40O | 9.91 |
| 22.191 | 9,12-Octadecadienoic acid (Z,Z)- | C18H32O | 1.879 |
| 22.321 | Oleic acid | C18H34O2 | 8.529 |
| 24.017 | Squalene | C₃₀H₅₀ | 2.795 |
| 27.378 | Miltefosine | C21H46NO4P | 0.363 |
| 27.543 | Vitamin E | C29H50O2 | 4.437 |
| 28.854 | Propanoic acid | C₃H₆O₂ | 0.323 |
HPLC analysis
We further wanted to confirm the presence of squalene in our extract. The modern analytic methods used for the quantitative determination of squalene are the chromatographic ones: high-performance liquid chromatography (HPLC) alone or coupled with mass spectrometry (HPLC/MS). Squalene, a hydrocarbon with the formula C30H50 hydrocarbon with six non-conjugated double bonds, presence in the extract was determined using HPLC. The HPLC profile of Acanthus ilicifolius methanolic extract is depicted in fig. 8. The profile of Squalene showed its characteristic peak at 8.843 and a similararea marked on the profile of methanolic extract showed the presence of Squalene in methanolic extract at a concentration of 0.460 ppm.

Fig. 5: HPLC graph showing the presence of squalene in the methanolic extract of Acanthus ilicifolius
Cytotoxicity properties of the extract
The GC-MS study of the methanolic extract of Acanthus ilicifolius shows the presence of numerous bioactive compounds. To determine whether the extract shows cytotoxic effects, HeLa cells were incubated with different concentrations of the extract along with doxorubicin (positive control). Post 24 h incubation, increasing concentration of the extract shows considerable cytotoxicity (fig. 6A). Further MTT assay showed only 53% cell viability in the presence of 400ug/ml of the extract which is similar in comparison to the positive control doxorubicin which showed 61% cell viability (fig. 6B).

A

B
Fig. 6: A) Effect of increasing concentration of methanolic extract of Acanthus ilicifolius and Doxorubicin (positive control) on HeLa cell line. B) Graph depicting percentage viability of HeLa cells in the absence and presence of the methanolic extract of Acanthus ilicifolius estimated by MTT assay
Wound healing activity
The proliferative activity of the extract was determined using wound healing assay. It was observed that within 24 h of addition to the cells, both Allantonin (positive control) and methanolic extract treated cells showed 36.68% and 51.53% wound coverage, respectively when compared to 8.58% in untreated cells. Upon further incubation, there was almost complete wound coverage in both Allantoin and extract-treated cells within 48 h, whereas only 32% wound coverage was observed in untreated cells (fig. 7).


Fig. 7: A) Image showing wound healing in the absence and presence of methanolic extract of Acanthus ilicifolius with time on L929 cell line. Allantoin is the positive control. B) Graph depicts the percentage of wound healing in the absence and presence of the methanolic extract of Acanthus ilicifolius with time
DISCUSSION
Mangroves are rich in secondary metabolites having wide applications for the treatment of diseases which could be due to the harsh conditions in which they thrive [15]. Acanthus ilicifolius is extensively found on Indian coastline. Our extracts showed the presence of all the major classes of secondary metabolites. This is in accordance with earlier reports [16, 17]. Our phytochemical analysis showed the maximum amount of phenols and flavonoids in the methanolic leaf extract. A recent report also shows high levels of phenols in methanolic extract of Acanthus ilicifolius [18]. The presence of these compounds could be the reason for the highest inhibition of DPPH observed in methanolic extract. DPPH activity of methanolic extract with IC50 value of 30µg/mg has been reported previously [16]. Another similar work using methanolic extract also reports high DPPH inhibition with IC50 of 49.73±1.14ug/ml [18]. Further, this extract showed antimicrobial activity against Klebsiella pneumoniae and Staphylococcus aureus. Similar observations have been reported [19] though they also showed a significant effect against E coli which was not observed in our study. Methanolic extracts have also shown effects against Salmonella typhi and Candida albicans [16]. GC-MS analysis of the extract showed the presence of numerous bioactive compounds as listed in the table 4. Previous observations also show the presence of numerous secondary metabolites upon GC-MS analysis of methanolic leaf extract [16]. Out of these, squalene presence was further verified using HPLC. Squalene, a triterpene is found in higher-order organisms as part of the cholesterol biosynthetic pathway. Squalene has been reported to protect skin from oxidative stress induced by free radicals. Its mechanism involves removal of free radical oxygen generated due to UV exposure and thus prevents lipid peroxidation [20]. Squalene is also reported to modulate lipid profiles especially reducing cholesterol levels thus serving as a potential cardioprotector [7, 21]. Further, the extract was shown to have cytotoxic activity against the HeLa cell line in our study, with about 53% viability in the presence of 400ug/ml of the extract as estimated by MTT assay. A recent report suggests that an effective concentration of 1000ug/ml or lesser in crude extract indicates the presence of promising anticancer activity [22]. The aqueous root extract of Acanthus ilicifolius has previously shown cytotoxicity against HEP G2 cell line [23]. Ethyl acetate extracts of this mangrove have shown a significant effect against breast cancer cell line MCF-7 [24]. Acanthus ilicifolius aqueous extracts have shown chemotherapeutic and hepatoprotection in xenograft models generated using the Ehrlich ascites cell line [25]. It will be interesting to identify the compounds responsible for the cytotoxicity effect in the methanolic extracts of Acanthus ilicifolius and also determine their mechanism of action. Wound healing scratch assay is used to determine the effect of drugs or extracts on cell migration properties of cells [26]. We observed promising cell migration activity as evident by similar effects on L929 cell line as Allantoin, a known positive control used to test for wound healing. Methanolic leaf extracts have shown a reduction in rat paw oedema in experiments indicating anti-inflammatory and wound-healing properties of the extract [27]. Methanolic extract from Acanthus polystachyus have shown wound healing effects in swiss albino mouse models [28].
CONCLUSION
The high levels of antioxidant, antimicrobial, cytotoxicity, and wound healing activities of the extracts of Acanthus ilicifolius shows it as an ideal plant source for use in medicine. It is imperative to further diverge into identifying the compounds present in the extract which could lead to the discovery of new potential drugs.
ACKNOWLEDGEMENT
The authors acknowledge the Director and the staff members of CBNR for providing the necessary support to carry out this research work.
FUNDING
Nil
AUTHORS CONTRIBUTIONS
All the authors have contributed equally.
CONFLICT OF INTERESTS
The authors declare that there are no conflicts of interest.
REFERENCES
-
Devi P, Syad AN. Botanics: a potential source of new therapies for Alzheimer’s disease? Botanics2014;(4):11-26.
-
Wu J, Xiao Q, Xu J, Li MY, Pan JY, Yang MH. Natural products from true mangrove flora: source, chemistry and bioactivities. Nat Prod Rep. 2008;25(5):955-81. doi: 10.1039/b807365a, PMID 18820760.
-
Mitra S, Naskar N, Chaudhuri P. A review on potential bioactive phytochemicals for novel therapeutic applications with special emphasis on mangrove species. Phytomed Plus. 2021;1(4):100107. doi: 10.1016/j.phyplu.2021.100107.
-
Xie LS, Liao YK, Huang QF, Huang MC. Pharmacognostic studies on mangrove Acanthus ilicifolius. Zhongguo Zhong Yao Za Zhi. 2005;30(19):1501-3. PMID 16335817.
-
Mastaller M. Mangroves: the forgotten forest between land and sea. Trop Press. 1997.
-
Babu BH, Shylesh BS, Padikkala J. Tumour reducing and anticarcinogenic activity of Acanthus ilicifolius in mice. J Ethnopharmacol. 2002;79(1):27-33. doi: 10.1016/s0378-8741(01)00347-6, PMID 11744292.
-
Lozano Grande MA, Gorinstein S, Espitia Rangel E, Davila Ortiz G, Martinez Ayala AL. Plant sources, extraction methods, and uses of squalene. Int J Agron. 2018;2018:1-13. doi: 10.1155/2018/1829160.
-
Palaniyandi T, Sivaji A, Thiruganasambandam R, Natarajan S, Hari R. In vitro antigastric cancer activity of squalene, a triterpenoid compound isolated from Rhizophora mucronata mangrove plant leaves against AGS cell line. Phcog Mag. 2018;14(57):369-76. doi: 10.4103/pm.pm_577_17.
-
Kabesh K, Senthilkumar P, Ragunathan R, Kumar RR. Phytochemical analysis of Catharanthus roseus plant extract and its antimicrobial activity. Int J Pure Appl Biosciences. 2015;3(2):162-72.
-
Subhan N, Alam MA, Ahmed F, Awal MA, Nahar L, Sarker SD. In vitro antioxidant property of the extract of Excoecaria agallocha (Euphorbiaceae). DARU J Pharm Sci. 2008;16(3):149-54.
-
Daoud A, Malika D, Bakari S, Hfaiedh N, Mnafgui K, Kadri A. Assessment of polyphenol composition, antioxidant and antimicrobial properties of various extracts of date palm pollen (DPP) from two Tunisian cultivars. Arab J Chem. 2019;12(8):3075-86. doi: 10.1016/j.arabjc.2015.07.014.
-
Vani M, Manikandan T. Phytochemical analysis and antioxidant activity of Acanthus ilicifolius. Int J Curr Res. 2018;10(12):76891-6. doi: 10.24941/ijcr.33406.12.2018.
-
Potterat O. Antioxidants and free radical scavengers of natural origin. Curr Org Chem. 1997;1(4):415-40. doi: 10.2174/1385272801666220126162734.
-
Popa O, Babeanu NE, Popa I, Nita S, Dinu Parvu CE. Methods for obtaining and determination of squalene from natural sources. BioMed Res Int. 2015;2015:367202. doi: 10.1155/2015/367202, PMID 25695064.
-
Saranraj P, Sujitha D. Mangrove medicinal plants: a review. Am Eurasian J Toxicol Sci. 2015;7(3):146-56.
-
Poorna CA, Maney SK, Santhoshkumar TR, Soniya EV. Phytochemical analysis and in vitro screening for biological activities of Acanthus ilicifolius. J Pharm Res. 2011;4(7):1977-81.
-
Handayani S, Najib A, Wati NP. Antioxidant activity assay daruju leaves extract (Acanthus ilicifolius L.) using 1,1-diphenyil-2-picrylhidrazil (DPPH) free radical stabling method. J Fitofarmaka Indonesia. 2018;5(2).
-
Aisiah S, Rini RK, Tanod WA, Fatmawati F, Fauzana NA, Olga O. Metabolomic profiling of Jeruju (Acanthus ilicifolius) leaf extract with antioxidant and antibacterial activity on Aeromonas hydrophila growth. J Appl Pharm Sci. 2022;12(8):57-69. doi: 10.7324/JAPS.2022.120807.
-
Pothiraj C, Balaji P, Shanthi R, Gobinath M, Suresh Babu R, Munirah AAD. Evaluating antimicrobial activities of acanthus ilicifolius L. and heliotropium curassavicum L against bacterial pathogens: an in vitro study. J Infect Public Health. 2021;14(12):1927-34. doi: 10.1016/j.jiph.2021.10.013, PMID 34756814.
-
Huang ZR, Lin YK, Fang JY. Biological and pharmacological activities of squalene and related compounds: potential uses in cosmetic dermatology. Molecules. 2009;14(1):540-54. doi: 10.3390/molecules14010540, PMID 19169201.
-
Chan P, Tomlinson B, Lee CB, Lee YS. Effectiveness and safety of low-dose pravastatin and squalene, alone and in combination, in elderly patients with hypercholesterolemia. J Clin Pharmacol. 1996;36(5):422-7. doi: 10.1002/j.1552-4604.1996.tb05029.x, PMID 8739021.
-
Gavamukulya Y, Abou Elella F, Wamunyokoli F, AEl-Shemy H. Phytochemical screening, anti-oxidant activity and in vitro anticancer potential of ethanolic and water leaves extracts of Annona muricata (Graviola). Asian Pac J Trop Med. 2014;7S1(1):S355-63. doi: 10.1016/S1995-7645(14)60258-3, PMID 25312150.
-
Paul T, Ramasubbu S. The antioxidant, anticancer and anticoagulant activities of Acanthus ilicifolius L. roots and Lumnitzera racemosa willd. leaves, from southeast coast of India. J Appl Pharm Sci. 2017;7(3).
-
Smitha RB, Madhusoodanan PV, Prakashkumar R. Anticancer activity of Acanthus illicifolius Linn from chettuva mangroves, Kerala, India. Int J Bioassays. 2014;3(11):3452-5.
-
Chakraborty T, Bhuniya D, Chatterjee M, Rahaman M, Singha D, Chatterjee BN. Acanthus ilicifolius plant extract prevents DNA alterations in a transplantable Ehrlich ascites carcinoma-bearing murine model. World J Gastroenterol. 2007;13(48):6538-48. doi: 10.3748/wjg.v13.i48.6538, PMID 18161924.
-
Martinotti S, Ranzato E. Scratch wound healing assay. Methods Mol Biol. 2020;2109:225-9. doi: 10.1007/7651_2019_259, PMID 31414347.
-
Mani Senthil Kumar KT, Gorain B, Roy DK, Zothanpuia, Samanta SK, Pal M. Anti-inflammatory activity of Acanthus ilicifolius. J Ethnopharmacol. 2008;120(1):7-12. doi: 10.1016/j.jep.2008.07.024, PMID 18703126.
-
Demilew W, Adinew GM, Asrade S. Evaluation of the wound healing activity of the crude extract of leaves of Acanthus polystachyus Delile (Acanthaceae). Evid Based Complement Alternat Med. 2018;2018:2047896. doi: 10.1155/2018/2047896, PMID 29991951.